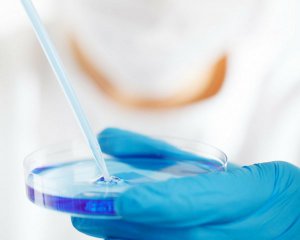
Учені довели, що є раніше не відомий стан речовини

Науковці з Констанцського університету в Німеччині відкрили новий стан матерії - рідке скло.
Учені вперше побачили дивну поведінку атомів цієї речовини, пише "Новое время".
Помилково скло вважають рідиною. Причиною цього є те, що деякі мінерали під час створення скла розігріваються і починають текти. Але в кінці скло все одно виходить твердим аморфним тілом із застиглими в хаотичному стані атомами.
ЧИТАЙТЕ ТАКОЖ: Український учений уперше отримав європейський грант
Дослідники з Німеччини підтвердили, що атоми скла можна змусити рухатися. У такий спосіб виявили новий стан речовини, яку поки що називають "рідким склом". Дослідження показує, що суміші деяких твердих частинок у рідинах можуть рухатися, утворюючи стан рідкого скла. Науковці проаналізували частки речовини при високих концентраціях і підтвердили, що вони блокують одна одну від обертання, але все ж можуть рухатися. Для атомів звичайного скла це неможливо.
"При певній щільності частинок їх обертовий рух застигає, у той час як поступальний рух зберігається, що призводить до утворення склоподібних станів, у яких частинки згруповуються у локальні структури з аналогічною орієнтацією", — пояснює провідний автор дослідження Андреас Зумбуш.
Подружжя науковців П'єр та Марії Кюрі 20 грудня 1898-го відкрили хімічний елемент радій. За нього подружжя Кюрі отримало Нобелівську премію. Вони понад 10 років займалися вивченням і видобутком радію і полонію. Полька Марія Склодовська закінчила Варшавський університет, за успіхи в навчанні стала стипендіатом університету в Сорбонні. П'єр - відомий французький фізик і хімік. Вони одружились і жили в Парижі.







































Коментарі